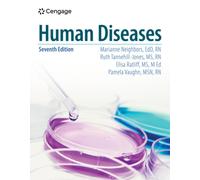
Human Diseases

£15.00
amazon.co.uk
Free Delivery

OBD2 Breakout Box, Automotive OBDII Protocol Detector Communication/Power/Ground Detection Breakout Box 16-Pin CAN 17.7 inches Cable Fault Diagnosis Scan Tool with Universal Wire Jumper and Clips
£39.99
Amazon-marketplace.co.uk
Free Delivery

Medical Diagnosis Otoscope Ear Care Speculum Magnifying Lens Clinical LED Lamp
£42.95
fruugo.co.uk
Delivery from £5.99

Annadue Hoof Check Gauge, Cattle Claw Gauge Ruler, Engineering Plastic Cow Hoof Trimming Measurement Tool for Farm Diagnosis, Livestock Ruler
£7.48
Amazon-marketplace.co.uk
Free Delivery

Annadue Hoof Check Gauge, Cattle Claw Gauge Ruler, Engineering Plastic Cow Hoof Trimming Measurement Tool for Farm Diagnosis, Livestock Ruler
£7.47
Amazon-marketplace.co.uk
Free Delivery

Larsen's Human Embryology
£62.69
Whsmith.co.uk
Free Delivery

Human Physiology
£73.14
Whsmith.co.uk
Free Delivery

Human Diseases
£75.04
Whsmith.co.uk
Free Delivery

Of Human Born : Fetal Lives, 1800-1950
£26.60
Whsmith.co.uk
Free Delivery

Making the Impossible Possible : My Work for Leprosy Elimination and Human Rights
£47.50
Whsmith.co.uk
Free Delivery
Human Diseases
£78.84
Whsmith.co.uk
Free Delivery

The Nature & Kinds of Autism Including Asperger's Syndrome : A deep understanding of Autism and Asperger's differences and causes. How to manage kids and adults with the syndrome and prevent it
£13.29
Whsmith.co.uk
Delivery from £3.99
🤖 Ask ChatGPT
🛍️ What are the most important purchase criteria?
💰 Tell me the best deals!
📋 Create a short summary!
Informations about "diagnosis: human: it’s"
Compare 15 bids for your search.
Pricehunter was able to locate products in 50 categories, ranging from £7.47 to £78.84.
About "diagnosis: human: it’s"
- In total, Pricehunter was able to locate 4 proposals, from providers such as Whsmith.co.uk, Amazon-marketplace.co.uk, fruugo.co.uk and amazon.co.uk.
- If you would prefer an item from a particular brands, you can find 2 online shops for this product. If you have not yet made a decision, you can also filter your favourite manufacturers and choose between 2 manufacturers.
- The most bids (2) were found in the price range from £7.00 to £7.99.
- Customers who looked for this item also found interesting.
- With our extensive colour palette you can select your favourite colour for your article. Of the available 0 coloration is the most frequently chosen.
Don't forget your voucher code:
Report Illegal Concerns
You are about to report a violation based on the EU Digital Services Act (DSA).